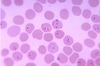

Parasitology Flashcards
(36 cards)
Which bacteria move using Phylum Ciliata?
- Balantidium Coli
- Paramecium
Which bacteria move using Phylum Amoebozoa?
- Entamoeba Histolytica
- Amoeba Proteus
Which bacteria move using Phylum Archaezoa?
- Trichomonas Vaginalis
- Giardia Lamblia
Which bacteria move using Phylum Euglenazoa?
- Trypanosoma
- Euglena
Which bacteria move using Phylum Apicomplexa?
Plamodium
What is a Fungi?
Molds (Multicellular fungi) classified into 2 groups based on their spore structure.
Fungi with Conidia have exposed spores.
Fungi with Sporangium have enclosed spores.
Spores represent asexual reproduction for fungi.
Can also reproduce via a different mechanism.
What is a Protozoa?
Classified based on their method of motility:
Cilia, Flagella, pseudopods, or none.
These eukaryotes can reproduce asexually (binary fission) and/or sexually(conjugation)
What is a Helminth?
Divided into 2 groups,
Nematodes(roundworms) &
Platyhelminths (Flatworms).
Nematodes are dioecious because they have seperate male and female worms.
Pltayhelminths are monoecious because each worm contains both ovaries and testes.
How do Ciliata move?
Using Cilia
How do Amoebozoa move?
How do Euglenazoa move?
By semi visible Flagella
How do Apicomplexa move?
No Motility
Balantidium Coli
– Bean shaped or bar shaped nucleus
– Cysts ingested from contaminated food/ water
– Causes diarrhea

Paramecium
– Free-living
-Sexual reproduction
(conjugation)
-Asexual reproduction
(binary fission)

Entamoeba histolytica
– Oval shaped
– Nucleus looks like a ring with a dot inside
– Causes diarrhea
Pseudopodia
not visible

Amoeba proteus
– Visible pseudopods (finger like projections)
– Free living

Trichomonas vaginalis
– Big round organism with a dense nucleus and flagella hanging off
– Causes trichomoniasis/ vaginitis

Giardia lamblia
– Tear drop shape, two nuclei, and multiple flagella hanging off
– Causes diarrhea

Trypanosoma
– S shaped squiggles among RBCs
– Causes African sleeping sickness (neurological condition)

Euglena
– Thin torpedo shaped organisms
– Free-living and photosynthetic

Plasmodium
– Ring like organism inside RBCs
– Causes malaria
Which type of worms are Heminths?
Platyhelminths (Flatworms)*
Nematodes (Round worms)*
Platyhelminths (Flatworms) 2 types
Trematodes (Flukes)
Cestodes (Tapeworms)

Types of
Trematodes (Flukes)
Clonorchis sinensis (liver fluke)
Schistosoma mansoni






